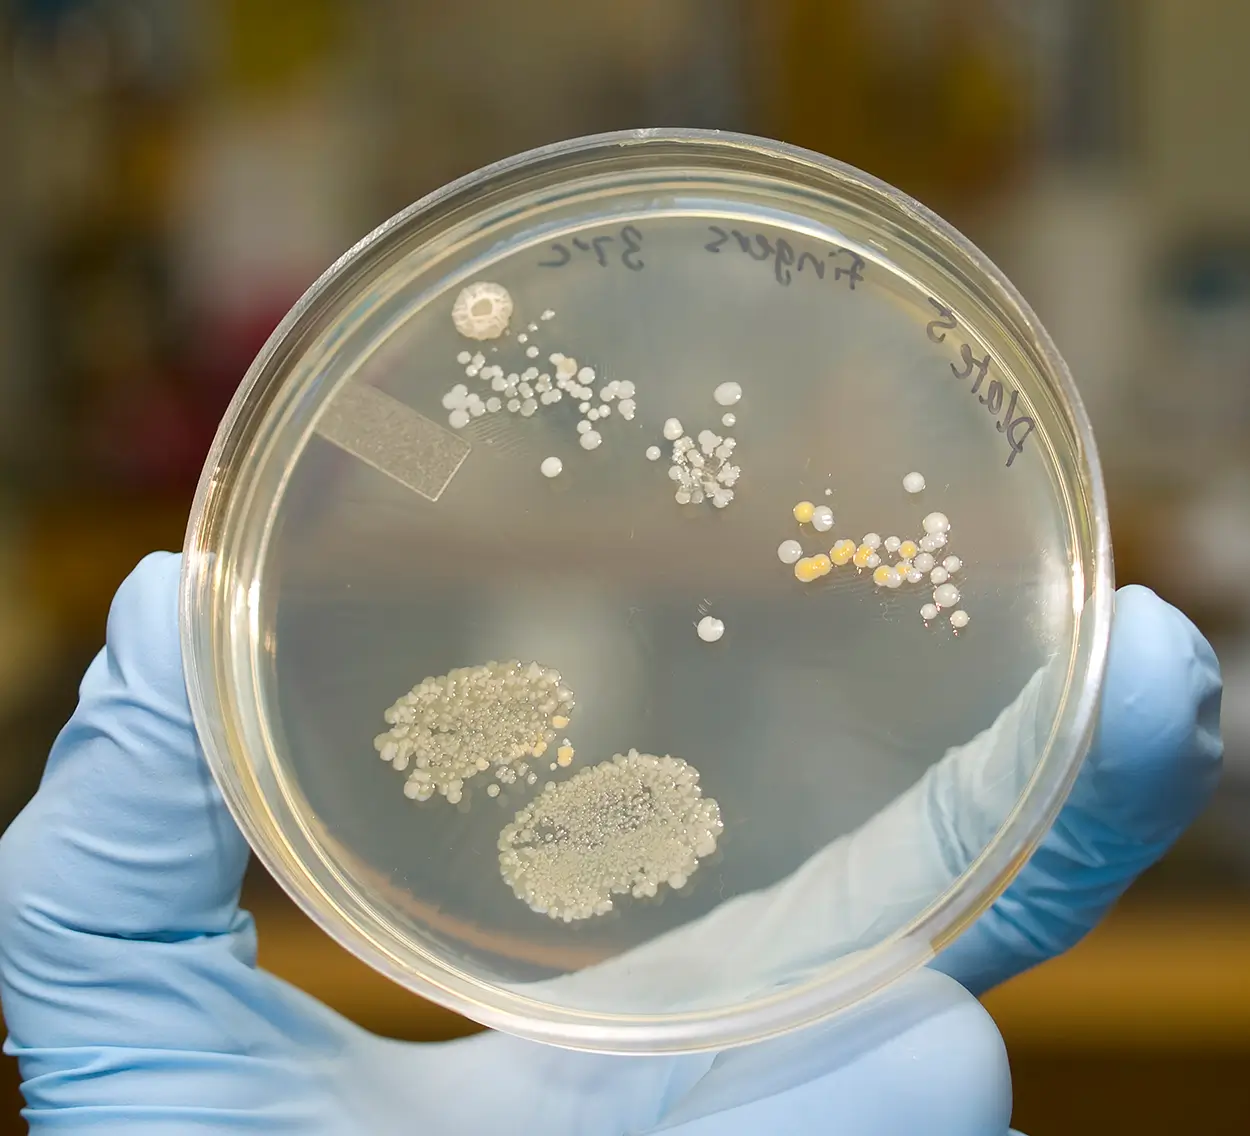

Water Testing Services
An Independent one-stop solution for your AS 5369:2023 testing requirements
For over a decade SEQ Laboratories has worked in partnership with Health departments and independent healthcare organisations to provide services to decontamination and sterilisation departments to the highest possible standards. SEQ Laboratories are industry leaders for innovation and are continually increasing our range of services including testing to AS 5369:2023 Table 7.2, Table 7.3 and Table 7.4. Providing impartial and objective reporting with excellent customer service.
Single point of contact
Put simply, you can now place all of your testing, auditing and certification of your medical equipment with a single independent provider rather than multiple device manufacturers - giving you more time to focus on patient care.
Fully qualified and experienced professionals
We have a team of competent testing microbiologists for all of your Environmental analysis needs.
Lower costs
Working with a single provider is far more productive and cost effective, therefore lowering your ongoing costs.
How we can solve your challenges
Testing
On site testing of all your decontamination systems including endoscopy, ultrasonic baths and many more. All personnel are fully qualified to the highest standards and currently serve major customers across Australia.
We offer a range of tests including:
- Monthly water Testing - Table 7.2 and Table 7.3
- Conductivity and Hardness Testing
- Pseudomonas Aeruginosa Testing
- Atypical Mycobacteria Testing (28-day culture grow)
- Endotoxin Testing
- Legionella Testing
